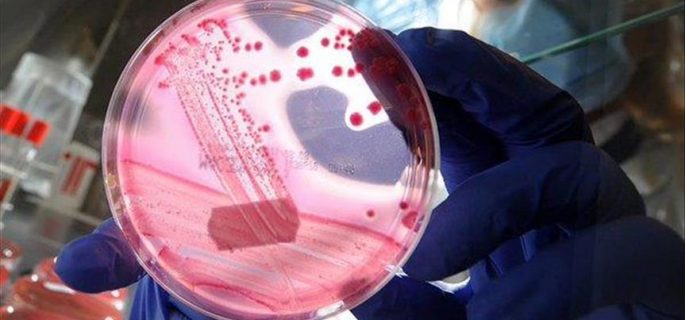

الاقليم يتخذ عدة اجراءات لمنع تفشي الحمى النزفية
محلي ـ الرأي ـ
اعلنت وزارة الزراعة في حكومة اقليم كردستان، الخميس، اتخاذ جملة من الإجراءات العاجلة لمنع تفشي فيروس الحمى النزفية.
وذكرت الوزارة في بيان، انه”من اجل منع تفشي مرض الحمى النزفية في اقليم كوردستان الذي ظهر في عدد من المحافظات العراقية، قررت الوزارة اتخاذ ستة إجراءات من بينها وجوب أن يكون ذبح الحيوانات في المجازر الرسمية بفحوصات وختم البيطرة الرسمي قبل أن يباع في الأسواق ومنع الذبح في الطرق وفي الازقة”.
واضافت، ان”فحص الحيوانات يجب أن يجري قبل وبعد عملية ذبح الحيوانات بهدف الاطمئنان من صحة الحيوان”، مشددة على”وجوب اتخاذ الإجراءات الصحية لفحص الملابس الخاصة والأدوات الخاصة بالذبح في المجازر الرسمية.
والزمت الوزارة، محاجر الحيوانات في المعابر الحدودية والمطارات أن تقوم بالفحوصات الدقيقة للحيوانات التي تدخل الى الاقليم بهدف الاطمئنان من صحتها.
واشارت الى، انها”ستتخذ اجراءاتها اللازمة بهدف تأمين ادوية غسل الحيوانات ومكافحة الطفيلي المسبب الرئيس لنقل فيروس مرض الحمى النزفية بين الحيوانات، مبينا ان هذه الحملة ستكون شاملة لجميع مناطق الاقليم”.
وأكدت على”السيطرة على ظاهرة استيراد الحيوانات بشكل غير رسمي من الخارج ومابين الاقليم وباقي المناطق العراقية، وكذلك منع استيراد الحيوانات من المحافظات التي ظهر فيها مرض الحمى النزفية”.انتهى
 طباعة الخبر
طباعة الخبر
 ارسال الخبر الى صديق
ارسال الخبر الى صديق
















